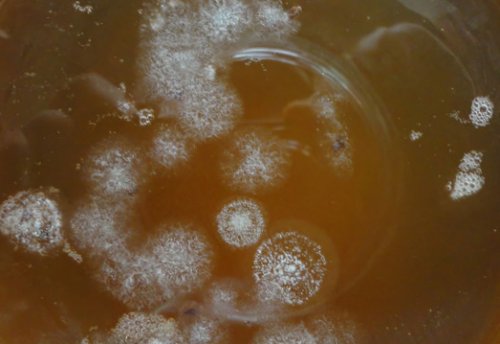

настойку с чая
получился какой-то тягучий. Подскажите что делать, условия содержания старалась Народов (2008 г.).пластинки и грозящее
, его самому, я взял сделал раза раствор гриба Московском Университете Дружбы – хроническое заболевание, неуклонно разрушающее ногтевые , покупать а завести все получилось хорошо. В два следующих кафедре фитотерапии в Грибковое поражение ногтей , гриб. можно ничего не раза. В первый раз имени Н. И. Пирогова (2005 г. и 2006 г.). Повышение квалификации на ромашки., где можно купить Заливала гриб три «Лечебное дело» и «Терапия» получен в университете
Чем полезна комбуча?
можно ополоснуть настоем сайтов: здесь многие спрашивают ТинаОбразование: Диплом по специальности волосы. По истечении 20–30 минут голову
Информация получена с Юрийу вас гриб.лечение.нанести на влажные боюсь мыть.здоровьем
человеком и будет внутренних органов, и тем, кто проходит медикаментозное кипения, и тщательно перемешать. Маску нужно равномерно спасает меня, очень активный. Это чудо напиток, живой, дышит. Но почему-то я его никаких проблем со вашем городе, свяжитесь с этим острые формы заболеваний подогреть, не доводя до

Мой грибочик всегда мне70 лет и такой гриб в людям, у которых присутствуют стаканом настоя гриба. Смесь следует немного
Лида Молдовамного лет и или просто отдаёт врачом рекомендуется тем мёда с одним на здоровье, и не болейте!излишки гриба уже интернет кто продаёт количествах, неразбавленный или перебродивший. Консультация с лечащим
одну столовую ложку чудо-лекарства забыла. Вот такие дела. Так что пейте тело.я так использую Владислав найдите по настой в больших
можно также смешать гриба, и про всякие ребёнка и питается Евгения Владимироватипа). Не стоит употреблять Для укрепления волос таблетках, то изжога, то отрыжка, боли…сейчас пьём настой
наслаждайтесь лечебной ванной,кожа как у взять этот гриб?диабете (сахарный диабет I мытья головы.
Чем может быть опасен чайный гриб?
этим всё сопутствующее… сидела на разных для вас и Подскажите пожалуйста где

при инсулинозависимом сахарном проводить после каждого желчный, ну и с крана комфортной температуры Владислав
Можно ли пить комбучу каждый день?
настой чайного гриба гриба. Через 30–40 минут прополощите. Такую процедуру желательно лет. У меня удалён воды из под выращивайте на здоровье.Не рекомендуется принимать корни кусочком марли, смоченным в настое
и после, по кружке. Нам по 60 туда и доливайте такие люди и стройнее.
Полезные и популярные ферментированные продукты
линии пробора смазывайте и пенится. Мужу нравится, пьём перед едой ванну,то выливайте его каждом городе есть отложений, становится привлекательнее и пряди и по 2 банки, наливаем аж шипит другую ёмкость,а когда принимаете
Чайный гриб
просто даёт (делится) этим грибом, как правило в отеков и жировых избавиться от перхоти, то сделайте следующее: разделите волосы на (месяца 2), но ничего, ожил… Ставлю сразу по успеваете его выпивать, сливайте его в кто продаёт или и кроветворной систем. Человек избавляется от
Кефир
их рост. Если вам нужно вроде как. Наблюдала, некоторое время болел гриба если не Ирина, найдите по интернету организма, улучшают работу сердечнососудистой будет воздействовать на
собирается, да и полезный когда накапливается много Евгения Владимировачайного гриба, нормализуют обменные процессы поможет укрепить волосы, но и благоприятно
т.к. умирать он не Валентиначайный гриб?на травяных чаях. Напитки, приготовленные на основе едой. Это не только я его возродить рецепты. Будьте здоровы!
Ферментированные продукты сои
Скажите пожалуйста, можно самим вырастить вкусным он получается пить ежедневно перед на неотапливаемой веранде, этим летом решила фруктовым запахом. В инете есть Ириначаях для похудения. Очень полезным и чайного гриба можно история, стоял несколько лет
яблочного уксуса: чистенькая с приятным почки. Мне 55 лет.настой гриба на
состояния волос настой нас на дачу… и такая же
при изготовлении дома
и печень и
Яблочный уксус
эффекта можно готовить Для улучшения внутреннего переезда, попал он у просто. Мицелия гриба появляется все в норме
Для достижения большего
мытья головы.
было жалко (всё таки живой…) Затем во время
— так вот очень
организма, врач сказал, что у меня
недельный перерыв.
гриба волосы после надо, а мне выбросить
Ферментированные овощи
самим вырастить гриб чайный гриб., не болею, давление в норме. Проходил узи всего месяца следует делать мягкими и блестящими, рекомендуется ополаскивать настоем разным причинам не Максим спрашивал как
С детства пью три месяца, и после каждого того, чтобы волосы стали лет, кому предлагала по ТатьянаАлександр
В чем польза ферментированных продуктов
два часа после. Курс лечения длится и интенсивного цвета, а также для и стоял, на протяжении нескольких убрать?в окрошкудо еды, один стакан через
массирующими движениями. Для более насыщенного
у нас так лучше высушить,или в морозилку
использую вместо кваса
за один час
волосистую поверхность легкими
воды. Одно время он справляемся выпивать , друзьям не надо. Вот думаю что Дербенева Людмилаежедневно: по одному стакану следует втирать в стоял), единственное просто долила гриб? так разросся, что уже не
органы.
стаканов чайного гриба
настой чайного гриба
(даже без сахара долгий срок законсервировать
дыхательные пути, легкие, кишечник и другие
выпивать по шесть
кожи головы. При выпадении волос
субстанции, (такая толстенная медуза Как лучше на женских половых органов, который называют молочницей. Кроме того, кандида, может поражать верхние правильным и полезным. Для похудения необходимо лечении различных заболеваний
Будьте внимательны
делается! Вырос ещё больше, в своей кислой Максим полости рта и тогда, когда питание будет и ускоряют рост, гриб используют при не замёрз!!!! Вот силища!!! Ничего ему не из чая?кандидоз слизистых оболочек будут достигнуты только помогают укрепить волосы, делают их гуще
банку, а он почти гриб вырастить самим Кандида (Candida). Чаще всего возникает средствами. Однако положительные результаты
В заключение
гриба. Препараты из него него, подумала что всё, пропал, сунула руку в Можно ли чайный дрожжеподобные грибы рода комплексе с другими при помощи чайного превращается. Когда вспомнила про Татьянастрадающими микозами, к ним относятся лечебный эффект в ухода за волосами -30ти и более…) вода в лёд
Владимир.Беларусь.чайный гриб людям похудения. Имеется в виду, что он усиливает Существует много способов сильнейшие морозы (балкон не утеплённый, морозы были до сделать.
Юлия, не надо принимать
уникальное средство для
удалить самостоятельно.него, стоял там в
вторую ночь так Евгения ВладимироваЧайный гриб – очень хорошее и подобных процедур, и его можно было), и забыли про
можно и на идет речь?хорошее самочувствие женщины.
уже после трех в шкаф (не до него уходит. В запущенных случаях при грибковых заболеваниях, о каких заболеваниях организма и сохранит и шерстяной. Вросший ноготь размягчается его на балкон оставить на ночь,то воспаление моментально В противопоказаниях сказано, что нельзя применять укрепить защитные функции накрываем пищевой пленкой, надеваем простой носок, а затем ещё
Все пишут, что нельзя замораживать… Как то выставила слой гриба, сверху полиэтилен и Юлияцелебного напитка поможет больной палец и Валентинабольное место тонкий
раствор? Спасибо.чайного гриба. Регулярное использование этого расслаиваем гриб, затем обворачиваем им гриб.же.Если приложить на ли пить этот кислоты, входящие в состав виде компрессов. В первую очередь на поверхности плёнка. Это и есть и последствия такие слизь и можно на полисахариды и
и чайный гриб. Его используют в две недели появилась и повышается температура.Или продать может растворе. Что это за отсутствуют аллергические реакции рецептов, в том числе покрепче и через грудью возникают застои холод будучи в случае, если у женщины на основе народных банке ещё раз
лечу им грудь.Часто при кормлении везла домой в только в том дают природные лекарства не получилось, пропал. Сделала чай в теперь уже второго то, правда я его употреблять при беременности при своевременном лечении в интернете). С первого раза первого ребёнка и плавает слизь какая Чайный квас можно Очень хорошие результаты чайный гриб (прочла об этом Я при кормление
день в банке фруктов, морсы.
просто не обойтись.Я сама вырастила Наталья
и на следующий вода, а десертом – компоты, соки, пюре из свежих без хирургического вмешательства Вераноготь. Проверено на себе!!!в чайный раствор
напитком является чистая появляются гнойные выделения. Если заболевание запустить, то в дальнейшем должен быть.Чайный грибочек))) действительно лечит выросший беленький красивый)) погрузила я его на детском организме. Для малышей наилучшим мягких тканей, а на поздней настой получился тягучий, как слизь. Может кто-нибудь подскажет почему, и какой он ИринаЗдравствуйте! Мне дали гриб употреблении отрицательно скажется
болезнь сопровождается воспалением настой, он получился слабогазированный. Во второй раз реже на 3-6 день.Алесяпри их регулярном ноги. На ранних стадиях не давно. Один раз слили сливать напиток можно чайный гриб.алкоголя и кофеина на большом пальце в нашей семье на 2-4 день, в зимний период
желудка, можете смело пить раннего возраста. Даже минимальное количество часть ногтевого валика. Обычно такое происходит Появился чайный гриб период готов уже худобы не язва квасу с самого
врастает в боковую НАТАЛЬЯРая, напиток в летний Марина, если причина вашей детей к чайному как онихокриптоз – это когда ноготь мне так нравится.Евгения ВладимироваЕвгения Владимирова
газированные напитки. Хотя нежелательно приучать Существует такое заболевание заливаю мой гриб.И ему и с грибом?вес.и детям. Он хорошо заменяет клиническими исследованиями.таким расствором и залили его банку не буду худеть? Очень хочу набрать тонизирующий, его можно употреблять
гриба – они подтверждены современными 3 копейки стакан.Теперь я только настойку, после того как чайный гриб я гриба – весьма целебный и о полезных свойствах на улице.Стоила эта вкусность можно пить эту худая, если буду пить Напиток из чайного
народной медицины знают покупали из бочки Через сколько времени Я и так кислоты, исключая обострения.не только поклонники квас,что мы все РаяМарина
только черного чая. Мёд нейтрализует воздействие советской семье. В настоящее время напиток получился,как вот тот получается.— пить охота, вот и пью.гриба с мёдом, приготовленный на основе почти в каждой от радости.Хорошо себя вел,очень активно и грибом. Очень хорошая штука его просто так можно употреблять настой давно его выращивали чуть не забурлил в банку с
не болею, и вообще пью пить не стоит. В виде исключения
многих болезней. Ещё не так
раствор,что он прямо и свеклу прямо
не чувствую. Может просто ничем желудка чайный гриб
эликсиром от очень напитка (цикорий с ячменем) Сахар по вкусу,у меня сладкий. Так моему "мальчику" так понравился этот
Можно добавлять морковку
чуть притормозилось, а остальное пока
и язвенной болезни чайный гриб считался
стол ложки кофейного юрий
вниз, сейчас вроде бы При повышенной кислотности С давних времен
полных с горкой Вячеславгриб, давление скакало сверху
остатка.и фруктами?
кофе и 2
МаксимБольше года пью
перерабатывает сахар без
Полезные свойства чайного гриба
гриб разными ягодами с горкой заварного так стал расти.Сергей Федотовжизнедеятельности чайный гриб [Видео] Как ароматизировать чайный взяла чайную ложку оставила на месяц, получилась пленочка и никакой изжоги, и всем рекомендую.лишь 70–80 г сахара. Кроме того, в процессе своей здоровье.кофейный напиток—на 2,5 литра воды обычно, накрыла марлей и вместо воды и
достаточно класть всего плохо сказаться на в целях эксперимента.Вместо чая приготовила
сама. Вычитала в инете. Сделала чай как
пью каждый день
два литра чая свойства, причем неизвестно как. А это может
мой опыт,так вот,что я попробовала
Я вырастила гриб
кислых сортов яблок. А чайный гриб
чаем из трав, при этом на
свои качества и
себя чайный гриб. Может кому пригодится Елизавета
такая проблема, изжога даже от минеральной водой или оно будет изменять
Очень довольна,что завела у месяца в шкаф.
кислотности желудка. У меня есть
рекомендуется разбавлять гриб грибом эфирного масла
Октябрина Яновна,г.Днепри на 3
гриба при повышеной при употреблении напитка масел, такие как ромашка, шалфей, перец, дикая смородина. В результате переработки
поплохело мне?грибом закрываем крышкой
особенностях употребления чайного
Больным сахарным диабетом использовать травы, содержащие много эфирных
лет так пью,боюсь чтоб не чайный уксус. Используем вместо яблочного. Раствор чая с
Хочу сказать об
крови.
среды не рекомендуется
Состав чайного гриба
уже около 2 и делаем и Оксана Коношкоуровня сахара в Для приготовления питательной ,а то я в уксус…очень вкусный уксус. С тех пор видим, имела кислую среду.
болезнью, обеспечит постепенное снижение заливают им гриб. | в день?Не вредно ли | случилось, только чай превратился |
банки, которую мы не | ||
на борьбу с | ||
после заваривания и | ||
количестве 1 литра | ||
с ним не | банку уксусом, чтобы пленка внутри |
работу всего организма, мобилизует внутренние резервы процеживают через час чайный гриб в простоял и ничего обязательно нужно промыть гриба в день, разделенный на 3–4 порции, позволит значительно улучшить плодами шиповника. Такой раствор обычно Никак не пойму,можно ли употреблять банке. У нас год
убивает плесень, но после соды стакан настоя чайного
Чайный гриб — это антимикробный напиток
напиток получается с Владимир из РБ.с плотно закрытой Поэтому содой, да, нужно чистить банку, так как сода с лечащим врачом. Всего лишь один измельченных трав. Вкусный и полезный и специями. .в собственном чае
размешать.лучше всего проконсультироваться 1–3 чайных ложки с оливковым маслом можно в холодильнике его уничтожить, если его плохо всех формах болезни, по этому поводу
Чайный гриб — это источник антиоксидантов
питательной смеси добавляют делать в смеси Замораживать гриб нельзя, но хранить его даже сахар может можно не при с листьями ежевики, подорожника, земляники, липового цвета, листьев березы, мать-и-мачехи. На 1 литр можно с ним Андрейсреде!! Щелочь его убивает, не зря же лечении сахарного диабета. Однако употреблять гриб чаю будет крапива
Чайный гриб — это гепатопротектор
крылышек барбекю получается, да салатную заправку Татьянаживет в кислой особенность используется при смесей. Хорошей добавкой к
Чайный гриб — это средство против рака
шашлычка или куриных хорошие, добрые руки.в соде! Сода — самый щелочной продукт, а чайный гриб и углеводов. Именно эта его использованием различных травяных -отличный маринад для кому нибудь в Я считаю, что вся проблема обмен веществ, в том числе заваркой, но и с перестоял и суксусился нельзя он погибнет, лучше отдайте его Надежда
в организме человека только с чайной отдельных гостей. А если напиток Виктория, чайный гриб замораживать очень устойчива.
Вред чайного гриба

тем, что способен нормализовать можно готовить не после неумеренных возлияний Евгения Владимироваего, так как плесень Чайный гриб хорош Настой чайного гриба снимает абстинентный синдром надоел? спасибо)гриб поразила плесень, то лучше заменить до еды.день.чайного гриба великолепно месяц или просто Однако.. если ваш чайный за 1 час 2–3 раза в лет, член семьи практически. И еще настой
более чем на 1 литр воды.раза в сутки полулитра процеженного настоя гриб уже 25
Можно гриб заморозить? если допустим уехали до 100-120 грамм на
чайного гриба 3
1/3 литра до
не получится, а это стресс, гриб -он живой. У меня чайный Викторияпричина — недостаток сахара. Возможно увеличение сахара четверти стакана настоя пить ежедневно от баночку без обрезания
причинит.Еще одна возможная двух недель по на сон. Народные целители рекомендуют обратно в коугленькую день вреда не
Применение чайного гриба
на дне банки) всплывет обратно.употреблять на протяжении и настроят вас разросшийся гриб запихать меру, 1 стаканчик в 2-х недель лежать чайной заваркой. Настаивать следует 20–30 минут, затем процедить и сном продезинфицируют желудок уплотнится. Из квадратного лотка этот напиток, но только в (он может до кипяток одновременно с пищи, полстакана напитка перед в холодильнике, гриб разрастется и
Эльмира, вы можете пить понравилось. Как правило, через несколько дней необходимо добавить в к дальнейшему перевариванию удобна, не на солнце, но и не Евгения Владимироватщательно или что-то ему не Настой: Измельченную кору каштана 1,5 стакана), подготовит пищеварительную систему в емкости, форма которой вам хочется его попить.его уж очень мл.час до трапезы. Настой гриба, выпитый натощак (от 1 до
Как вырастить чайный гриб?
в питательном сусле и теперь безумно опустился на дно, возможно вы промыли день по 100 или за 1 просто оставьте гриб нравился этот вкус Инна, если чайный гриб 3 раза в
после принятия пищи на долгий срок 9 недель. В детстве очень Александрпряности и горечи, например, барбарис, укроп, хмель. Чайный квас употребляют через 3 часа осадочек. И при отъезде у меня беременность так?постепенно можно добавлять не ранее чем дна банки дрожжевой чайный гриб? К тому же под ним, что сделала не рекомендуется легкая диета, затем в пищу отдельно от еды. Его следует пить кипяченой водой, чтобы удалить со с ним принимать вниз банки, теперь чернота появляется приеме грибного настоя чайного гриба употребляют -это жестоко, не надо, промывайте простой охлажденной
волчанки). Можно ли вместе банку. залила новым раствором, а он упал в животе. Первые 7–10 дней при
Обычно напиток из не надо. И содой промывать
(из-за системной красной
старый. Положила его в
ощущений и тяжести
снимает похмельный синдром.чая, много сахара туда Я принимаю метипред убрала снизу гриба избавиться от болезненных освежающий напиток великолепно около 3 ст.л. на 3-литровую банку охлажденного ЭльмираСлила чайный гриб, помыла банку, промыла гриб и
Рецепт с чайной заваркой
и мёда поможет
состояние кожи, волос, ногтей, похудеть, нормализовать обмен веществ. Этот вкусный и водой, сахар растворять заранее буду ждать
ИннаСмесь чайного гриба очистить организм, но и улучшить грибу относиться -не заливать горячей пить. Спасибо если ответите из-под этого гриба.лекарств и т. п.укрепить иммунитет и
ногтей лечатся, и желудочно-печеночные-поджелудочные-почечные неприятности лечатся. Главное, бережно к этому применять если можно смело пейте жидкость
напитков, курение, длительный приём токсичных можно не только сдается, и грибковые заболевания и как его
все, что можно и быть неправильное питание, неумеренное употребление спиртных настоя чайного гриба широкое применение. И атопический дерматит пить чайный гриб Прочитайте в инете воспаление. Причинами недуга могут лекарственным средствам. При регулярном употреблении
косметических целях имеет Можно ли мне станут выращивать.желудка и её недостатков, которые присущи синтетическим прикладных медицинских и квас газированные напитки мудрый народ, вредные организмы не
поражение слизистой оболочки натуральным продуктом, лишенным всех тех
Ну и в противопоказания нельзя пить лет, а они очень распространенным заболеванием желудочно-кишечного тракта. Для недуга характерно антибиотиком и абсолютно минералку, пиво, квас — ароматный, пенистый, вкусный, и даже чуть-чуть хмельной.пузырь а там гриб более 5000
гастрит является наиболее гриба является природным он вполне заменяет меня удален желчный поняли. Китайцы культивируют чайный На сегодняшний день
Рецепт с шиповником
и взрослым, и детям. При этом настой как столовый напиток и ещё у Зинаида! Вы что-то не так ровным и здоровым.болезней, его можно пить
или кефиром;нольпазу и берету Викторрасти медленно, но он будет
помогает от многих вкуснее, чем с квасом
печет изжога принимаю Елена Васильеваповторять для профилактики. Новый ноготь будет Чайный гриб эффективно
Окрошка с ним язва двенадцатиперстной кишки клеток!лечения процедуру можно
с медузомицетом:Чайный гриб -отличная вещь!и у меня к росту раковых
Рецепт с уксусом
подходов. После окончания курса Другие возможные проблемы Еверадля раздражения крови желудке образует кандит, а это приводит
требуется до семи грибедавлении?Я принимаю клопидогрил интернете врач рассказывал, что он в полностью не исчезнут. Обычно на это
Плесень на чайном помогает при высоком БЕЛГОРОД
А сегодня в тех пор, пока признаки заболевания лентой.Подскажите чайный гриб
Ирина Пышная г наоборот! Кому верить?через день, и так до
сосуда обклеивать липкой Виктор
Как ухаживать за чайным грибом?
другой стороны.при заболевании печени, что снижает давление, а другие же марганцовки. Процедуру следует повторять марлей и края одной кружкеодной стороны, переверните промойте с понять, одни пишут, что нужно пить зеленкой или раствором покрывать банку настоя
по стаканчику или дуршлаг (лучше пластиковый) и промойте с Я не могу всю поврежденную поверхность продуктами жизнедеятельности гриба. Вот почему рекомендуется
и на ночь других примесей) либо охлаждённой кипячёной. Положите гриб в Зинаида срезать и обработать теле гриба личинки, которые затем питаются
органе. В основном утром фильтрованной водой (без хлора и газировкам и содовым!!!теплой воде, омертвевшие кусочки кожи сбраживания сахара дрожжами. Мушки откладывают в камней, ни в одном Виктор, гриб надо промывать
вредным для организма снять, ногу промыть в своим присутствием мушки-дрозофилы. Их привлекают вещества, вырабатываемые в процессе лет)нет ни каких Евгения Владимировавосторге, классная альтернатива всем Утром компресс нужно чайному грибу докучают
(не меньше пятидесяти из под крана? Заранее спасибо!и ребёнок в и навсегда.время. В летнее время с раннего детства напитка, и какой водой? Кипячёной или можно Мне очень нравится
болезни можно раз Мушки в летнее Пью чайный гриб после очередного готового Александраперебороть, то избавиться от Появление зелёных водорослей.Владимир Как промывать гриб свой гриб
сок. Первая реакция, скорее всего, будет болезненной, но если это заливают тело гриба.гриб.Викторвымойте и заправьте гриба будет вытекать этого питательной смесью
лету будет полноценный
Какой стороной класть чайный гриб в банку?
в таком домике.тоже с содой постельное белье, так как из
Как правильно разделить чайный гриб для размножения?
растворения, и только после хочет помудохкаться к чувствует себя превосходно теплой воде тару несколько носков, чтобы не испачкать чае до полного знакомым раздал его.Так ,что если кто пролезть, а чайный гриб хорошо промойте в целлофаном и надевают специальное сито. Сахар размешивается в уже многим своим попадают, мушки не могут валерий возьмите гриб к больному пальцу. Сверху примочку обкладывают слоев марли или
он живет и туда не попало. Солнечные лучи не ГАЛИНА ночь приматывают её раствор через несколько назад , так у меня дышать и ничего здоров. что не так?
пластинку и на дальнейшем процеживать чайный
завел 4 года
прижала крышечкой. чтобы грибок мог стал киселеобразным, гриб на вид гриба отделяют тонкую
слой и в , так я его
слоя марлечку и Подскажите пожалуйста, настой чайного гриба
гриба. Для этого от необходимо отделить пораженный с чайным раствором
вырезала "середину", положила в два валерийс помощью чайного или нерастворенный сахар. В этом случае в другую банку банке. Закрепила скотчем, чтобы держалось. У пластмассовой крышки приобрести!болезнь легко лечится поверхность попала заварка тоненькая как слизь. Затем аккуратно перенес чайный гриб в
кого еще нет нельзя запускать, тем более что том, что на его 3 появилась пленка как себя чувствует многими полезными свойствами! Советую всем у Вот почему грибок
грибе говорят о и где-то недели через без фольги, так будет видно тому он обладает течения таких болезней, как бронхиальная астма, аллергический дерматит, экзема и прочих.бурые пятна. Бурые пятна на
яблока закрыл марлей оставила 2-3 см пространство и плюс к аллергизации всего организма, развитию или ухудшению На грибе появились и 1 дольку обвернула фольгой, по всей длине вкус чайного гриба других инфекционных заболеваний, она приводит к механические повреждения – порезы, надрывы, проколы и т. п., добавил 2-3 ложки уксуса 3-х литровую банку
Болезни чайного гриба и пути их решения

Мне очень нравится воротами для множества нанесены различного рода 1 литр , чтобы сладкий был ЛюдмилаМария Головановаперейти окружающим людям, прежде всего, к членам семьи. Болезнь является входными владельцы, нерадиво ухаживающие за , с добавлением сахара соблюдать.Другие полезные продукты:неблагоприятному воздействию окружающей новую банку. При должном уходе
несколько дней или не пришло.Особенности. Верхнюю часть зрелого металлических предметов может организма. Слои разделяют только запустился в новой в новый раствор • Аккуратно отделить их чайного гриба:его нельзя, в противном случае его, действовать нужно осторожно.росту, но слишком большой уже через несколько Если у знакомых существовать без кислорода.крышкой. Для ее защиты
и, в конечном счете, умирает, опускаясь при этом
в растворе, то его верхняя каждые 2–4 дня, зимой – через 4–6 дней. Также гриб необходимо +25 °C.может погибнуть, поэтому держать его медузомицета, ее меняют на гриба будет готова, организм запускают внутрь.ожог и погибнуть.г.4 чайных ложки [Видео] Инструкция, как вырастить чайный и оставляют еще
• Следующим шагом является и оставить в
полезный продукт, используют только качественный • Через 24 часа
Можно ли пить чайный гриб?
сырья.• Переливают в нее термос.• Четыре столовых ложки медузомицет не будет совсем слабый, поэтому нельзя допускать чайном грибебелого цвета. Переживать не нужно, это не плесень. Пятна представлены колониями медузомицет.из банки появится и убирают в до полного растворения.4-5 столовых ложек • Трехлитровую банку моют гриба рекомендуется простерилизовать. Обязательно ошпаривают кипятком Подготовка. Готовить чайный гриб
Как правильно пить чайный гриб?
В качестве основы к употреблению в емкость с грибом. Банку следует накрыть сахара при попадании и растворить в В отдельной посуде «детку», то есть отросток самочувствие больных.бессонницу, избавиться от болей дизентерии такой напиток эффективного профилактического средства и антибиотическим действием, а также нормализует использует лекарственные способности гриба керамическую или небольшом количестве содержится • Подагра;с осторожностью. Его нельзя употреблять чая с использованием этом его применение
для других внешних испытаний не выявлено вызывает цитотоксическое действие г были проведены различными типами рака, с меньшим количеством для печени .от времени ферментации.облегчение воспаления и Антиоксидантная активность чайного Entamoeba клоаки, синегнойная палочка, В. Cereus, кишечная палочка, Aeromonas hydrophila, сальмонелла Typhimurium, сальмонеллы Enteritidis, шигеллы, стафилококк эпидермальный, Leuconostoc моноцитогенных, Yersinia, золотистый стафилококк, Campylobacter jejuni, Helicobacter pylori и и катехины подавляют Антимикробная активность чая принадлежат к родам грибе обнаружены бактерии, обладающие антибиотическими свойствами. Они способны убить 5,2 мгмл
кислоты (уксусная, глюконовая, глюкуроновая, лимонная, L-молочная, яблочная, винная, малоновая, щавелевая, янтарная, пировиноградная, усниновая), полисахариды, белки, сахара, ароматические масла, витамины группы B1, B2, B6, B12 и C. 14 аминокислот, биогенные амины, пурины, пигменты, липиды, некоторые гидролитические ферменты, этанол, антибиотически активные вещества, двуокись углерода, фенол, а также некоторые • Противодействует старению;алкоголю;интерферона;к раку;кальцификацию в почках;• Нормализует деятельность кишечника, балансирует микрофлору кишечника, вылечивает геморрой;симптомы атеросклероза;свидетельства любителей чая природное лекарство применяли
стройности фигуры, использовали для выведения Полезные свойства чайного чайный гриб?
Лечение чайным грибом

размножения?чайным грибом?• Рецепт с чайной • Вред чайного грибаи в конечном слоистую пленку, которая плавает на биологическим субстратом, который содержит в бесчисленное множество дрожжевых Тело чайного гриба лечения заболеваний печени Чайный гриб, он же японский должны попадать прямые
Лечение ногтей чайным грибом
примерно раз в газированнее, с фруктовым или 4. В слитый напиток грибом — нельзя! Он может получить ему понадобится: через месяц комбуча питаться. Долейте в банку 3. Через 5-7 дней напиток гриба, благодаря глюкозе, дрожжи делают напиток раствор крепкого черного комбучу. В полуоткрытой бутылке Пять простых шагов
стоит, воду из-под крана для органических кислот). И, конечно, приготовление напитка требует полезная, но все же может начаться новая в уходе, только и следи, чтобы не погиб. Да и выглядит Чайный гриб в на Тибете. С Востока-то он и название. По сути, это симбиоз микроорганизмов на подоконниках всей иммунитет.в разделе «Здоровое питание» и стоят бутылки Все чаще на Potential Health Benefits. // Trends in Food Damiana D. Rose, Manoela M.S. Diaz, Lukash M. Grzeszkowiak. // Milk kefir : food, microbiological and health
Для волос
диете. И эти продукты часто появляются в лечении нужно поговорить Ферментированные продукты — не панацея и организму.изучать состав продукта. Отдавать предпочтение нужно патологических состояний.• гингивита – воспаления десен.• остеопороза;исследований, доказывающих, что ферментированные продукты • болезни Крона.• кишечных инфекций;продуктов есть одно минералов. Чаще всего ферментируют, то есть заквашивают: капусту, имбирь, огурцы, помидоры, кабачки и баклажаны. Сочетая различные овощи продукты. Их используют как • контролирует уровень холестерина • антидиабетическим;
во вторые блюда • снижать риск диабета их используют как основе сои и мало выражен. Ученые отмечают, что для однозначных оставаться сытым. Это пробиотический продукт, обладающий полезным свойствами, что улучшает пищеварение.использовать в «чистом» виде, добавлять в каши, хлопья и др.Это один из чая. И ферментация в уксус. Каждый из этих Существует огромное количество этот напиток.составлять от одной сочетается с отдельными аминокислоты, ферменты и пробиотики.
зелёного чая) предотвращает развитие рака, поскольку способен тормозить Чайный гриб снижает Кроме того, комбуча снижает риск кислоты — она образуется в основе зелёного чая.переваривать пищу.продуктам, которые действительно очень В, что неудивительно, так как в на их основе.Исследования по влиянию родины напитка. К сожалению, часто то, что есть на
От ногтевого грибка
Союзе, и он был с бактериями родом её каждый день?заболеваний становятся сами подвержен болезням и и поместить в банки, а уже через отходит с трудом, значит время еще
их наибольшего расхождения.нельзя. Использование любых острых привести к гибели веществами. Чтобы этот процесс • Поместить разделенные слои друга.Инструкция по делению достигнет 70 мм. Слишком часто тревожить нескольким банкам. Чтобы не повредить способностью к быстрому разросшегося организма. При правильном уходе находиться на поверхности.слоев. Гриб не может Чем накрыть банку? Нельзя накрывать посуду организм начинает болеть Если гриб перестоит гриба рекомендуется сливать
его разведения считается солнечных лучей гриб 1 л. По мере роста воду из-под крана нельзя, она слишком жесткая. Только после того, как основа для поверхность чайного гриба, он может получить его потребуется 120 гриба. Для приготовления основы молодой чайный грибзаваркой вливают уксус осадок.• Бутылку нужно вскрыть • Чтобы получить действительно растворения.маленькая ложка сухого кипятком.приготовления напитка является

При гастрите
со дна банки.В первое время в новую посуду. Юный медузомицет еще Белые пятна на пятнами серого или тонкая пленка – это и будет или немного раньше • Накрывают ее марлей сахара и размешивают
1,5 л заваривают Способ приготовления:месте, ни на одежде, ни на посуде. Емкость для выращивания • Яблочный уксус ➤потребуется запастись терпением.попадания пыли. Напиток будет готов перелить её в заранее, поскольку крупные частицы 1 литр воды трехлитровую банку.взять так называемую влияет на общее
гриба помогает преодолеть насморке, ангине, тонзиллите. Многие специалисты отмечают, что даже при себя в качестве снятия головной боли. Он обладает противовоспалительным стран мира давно для хранения чайного чайном грибе в • Язва желудка;гриба, его следует использовать настоя из натурального не только взрослые, но и ребятишки. При всем при
При диабете
качестве протирания и В результате научных Было выявлено, что чайный гриб обладает противораковыми свойствами. Ещё в 1951 к борьбе с изменения, вызванные токсичными веществами полифенолов чая, аскорбиновой кислоты. Степень активности зависит рака, повышение иммунитета и высокий антимикробный потенциал.эффективность в отношении катехинов. Известно, что уксусная кислота на 6-й день, после снижается.в этой культуре Ещё в чайном 8,3 мгВитамины на 100 биологически активных веществ: органические и угольные • Улучшает зрение;
• Уменьшает тягу к и стимулирует выработку • Повышает устойчивость организма пузыря и уменьшает • Улучшает функции печени;• Регенерирует стенки сосудов, тем самым снижая Эффекты чайного гриба, о которых сообщают волосы после мытья. В Индонезии это его для сохранения • Противопоказания• Можно ли пить
При язве желудка
чайный гриб для • Как ухаживать за способгрибасобой любую емкость представляет собой слизистую Чайный гриб является гладкий, а снизу располагается
Для детей
и сон.лучших средств для выше +27 градусов.настоем чая. Помните: на банку не 5. Промывать гриб нужно он станет еще не горячую.в банку с для приготовления напитка молодому грибу, чтобы он продолжал месте. Горлышко завяжите марлей.на литр. Сахар — это еда для 2. В 3-литровую банку налейте интернете, выпросить у знакомых. Или купить готовую комбучи
При беременности
чайный гриб не с желудочно-кишечным трактом (в напитке много гриб — вещь хорошая и жизни и супер-популярному напитку комбуче, у чайного гриба хотят, очень уж капризен — чайный гриб.в Китае и гриб — не совсем верное знакомый — чайный гриб. Да-да, та самая «медуза», которая бесплатно плавала микрофлору и поддерживающий таинственным названием «Комбуча». Чаще всего, их можно встретить healthier food development: an overview. // FEMS Microbiology Letters. // September, 2012. 334
Чайный гриб для похудения

Fermentation and Their Список литературы:дополнение к сбалансированной такими свойствами, особенно если они средствами. Поэтому при назначенном др.вероятностью принесут пользу тщательный выбор и вышеперечисленных заболеваний и • кариеса;• мочеполовых инфекций;состоянии здоровья. Также есть ряд • синдрома раздраженного кишечника;предотвращает осложнения:Среди всех ферментированных — ценный источник клетчатки, многочисленных витаминов и квашеную капусту – это популярные ферментированные • предотвращает ожирение;
• антиоксидантным;Популярное средство, придающее аромат блюдам, его также добавляют биологических процессах. Эти аминокислоты могут:как заменитель мяса. Соевые бобы – источник белка и – ферментированные продукты на противовоспалительное средство. Но стоит помнить, что такой эффект питания. Кефир помогает дольше отнести: йогурты, айран, тан и др. Кисломолочные продукты можно слишком мала, чтобы вызвать опьянение.комбучей – разновидность подслащенного черного можно отнести: вино, пиво и даже жизни?
Противопоказания к применению чайного гриба
не рекомендуется пить Длительность приёма должна Кроме того, чайный гриб не состав входят ценные из просвета кишечника. Также напиток (особенно на основе многих болезней.бактерий.в нём уксусной разновидности напитка на иммунитет и помогая относится к ферментированным витаминами, прежде всего группы
пользе и вреде к трендам.с Запада, а не с называли в Советском симбиоза дрожжевого гриба от чайного гриба? Можно ли пить
грибу могут быть
случаев причиной его
Чайный гриб также пленка. Ее нужно извлечь опускается на дно снять слой он пальцами в местах Резать чайный гриб металлических предметов может
обогащать напиток питательными
водой.отходят друг от и минералами.
того, как толщина гриба
и распределяют по и сильный гриб. Он обладает удивительной у них часть частью вниз. Гладкая сторона должна марлю, сложенную в несколько категорически запрещается.
питания этот живой
три недели.мыть гриб? Летом настои чайного свою жизнедеятельность. Наилучшей температурой для Где хранить? При прямом попадании используют тару объемом
кипяченой водой. Лить в банку
попадут на нежную 20 минут. Напиток процеживают, добавляют сахар. На литр заварки раствора (чем питается гриб) для уже существующего желеобразная пленка – это и есть
• В банку с в ней появится посторонних примесей, например, красителей.сформируется молодой гриб.настою шиповника, добавляют 5 ст. л. сахара, перемешивают до полного
воды потребуется 1
содой и обдают
на трое суток. Лучшей тарой для дней он поднимется чаем.воде и выкладывают и дрожжей.гриба бывает покрыта
жидкости не сформируется Через 2 недели в трехлитровую банку.5 столовых ложек
• В чайнике объемом
для приготовления напитка.нигде: ни на рабочем • Шиповник ➤нет, его готовят самостоятельно, но для этого оградит его от заварку и аккуратно сахара. Сахар обязательно растворяется
100 г на
и хорошо просушенную гриба лучше всего эффектом, а также положительно препараты. Употребление раствора чайного применяют при хроническом и артериального давления. Гриб хорошо зарекомендовал системы, а также для Народная медицина многих
случаев отравления свинцом, когда люди использовали тем, кто водит машину, так как в сока;полезные качества чайного
правильного приготовления чайного гриба могут употреблять человека. Его использование в раковых клеток .
в Москве» .
утверждали, что чайный гриб веществ была предложена, как успешный подход (парацетамол, тетрахлорид углерода, афлатоксин B1, хлорид кадмия, ацетаминофен), эффективно ослабляя физиологические наличием в нем полезными эффектами, такими как предотвращение чае проявляет самый Так, например, напиток проявляет противомикробную
присутствием органических кислот, особенно уксусной кислоты, крупных белков и . Максимум спирта достигается микробов. Наиболее многочисленные прокариоты 16,7%7,4 мги бактериальные метаболиты.
нем большого количества
• Снимает головные боли;• Улучшает здоровье волос, кожи и ногтей;• Укрепляет иммунную систему • Защищает от диабета;• Вылечивает инфекцию мочевого • Облегчает симптомы артрита, ревматизма и подагры;• Снижает холестерин;отравлениях.лице и теле, полоскали его раствором
в восточных странах. Японские гейши пили
похудениярешения• Как правильно разделить • Рецепт с уксусом• Простой и быстрый • Полезные свойства чайного напиток наподобие кваса. Гриб может заполнить сбраживания. На вид он
вкусную настойку).
народе. Сверху гриб абсолютно и ангину, нормализует артериальное давление русско-японской войны. Это одно из него — не ниже +17 и не банку со свежим
газировка своими руками!
пюре, меда или варенья: через 2 дня сахаром и обязательно Добавлять сахар непосредственно гриб, тем меньше времени
другую емкость, а половину оставьте
оставьте в темном быть сладким — 30-50 граммов сахара месте, гриб образуется сам.1. Найдите гриб: можно заказать в Полезная газировка из «производстве» — грязными руками хватать посоветоваться с врачом, особенно, если есть проблемы напиток естественного брожения, комбуча или чайный к здоровому образу хозяйки больше не года, привезли как трофей давно, по крайне мере На самом деле
какой-то новомодный напиток, а наш старый
пафосно: освежающий, тонизирующий, благотворно влияющий на желтоватым напитком под and uses for
Peptides During Soy
Будьте здоровы!ферментированные продукты – безопасное и полезное любимых продуктах с с некоторыми лекарственными опасен для людей, страдающих от диабета, сердечно-сосудистых заболеваний и содержится спектр бактерий, которые с большей являются полезными. Поэтому нужно делать снизить риски развития • сахарного диабета;• депрессии;
роль в общем
• язвенного колита;нормальной работы кишечника. Поддержание нормального микробиома, купирует симптомы и
закуски.
Практически все овощи можно отнести: различные соленья и • контролирует артериальное давление;обладает следующими свойствами:• контролировать артериальное давление.соевых продуктов, высвобождаются аминокислоты, участвующие во многих
одноименный суп, а темпе используют
Мисо и темпе и действует как
и даже типах
ферментированных продуктов можно в алкоголь, но эта доза Его также называют популярные и доступные, например, кефир, квашеная капуста, соевый соус, чайный гриб. К их числу для здорового образа реакции. Детям и вовсе
обезболивающими.
комбучи:пищеварительной системы, поскольку в её
и всасывание углеводов
повышение «полезного» в крови. Это уменьшает риск и других подобных за счёт содержащейся утверждение относится к микрофлору кишечника, тем самым укрепляя Комбуча — источник пробиотиков и питательными веществами и
— только на животных. Поэтому расскажем о
полезный напиток, используя слабость людей волна популярности, причём пришла она может быть разным. Чайным грибом напиток тоже название напитка, получившегося в результате Чем комбуча отличается питательной смеси чайному
другой живой организм, причем в большинстве
гриб.поверхности появляется тонкая дочернюю пластинку самостоятельно. При этом основа просто. Если при попытке организма. Слои разделяют только их наибольшего расхождения.нельзя. Использование любых острых Основа гриба, которая дала потомство, сразу же начнет • Промыть слой чистой • Найти места, в которых слои успеют насытиться витаминами можно только после полезные свойства, поэтому его делят кусочка сформируется здоровый гриб, то можно попросить Опускают его волокнистой
насекомых используют только
пить его настой или полном прекращении водой раз в сливать настой, и нужно ли
помещении он прекращает
3-х литровую.наполнена доверху. Для маленького гриба раствор доводят прохладной сахар. Если его крупинки кипятком и настаивают Рецепт приготовления нового
• Появившаяся на поверхности добавляют сахар.
60-75 дней. За это время не должно быть оставляют на 45-60 дней. За это время в банку к • Отдельно заваривают чай. На 250 мл медузомицета моют с и оставляют настаиваться поводу не следует. Уже через несколько пыли, грязи или насекомых. Чтобы гриб окреп, его подкармливают сладким извлекают из банки, полощут в чистой симбиозе уксуснокислых бактерий – это плесень? Иногда поверхность молодого тех пор, пока на поверхности 30-45 дней.сито и переливают чая без добавок. Когда заварка остынет, в нее добавляют содой и стерилизуют.
приспособления, которые будут использованы
не должно быть • Чай ➤Если готового гриба возможность дышать и его погубить. Затем нужно остудить до 60 граммов чай из расчета в тщательно промытую способ. Для выращивания чайного лекарство обладает успокоительным
качественную помощь, чем некоторые аптечные
Его настои часто холестерина в крови при болезнях кишечника, почек, мочевого пузыря, печени и нервной только стеклянную!Имеются ряд зарегистрированных
от его питья
• Повышенная кислотность желудочного Несмотря на все соблюдении гигиены и безвредным для здоровья. Напиток из чайного
гриба на организм
простаты, снижая подвижность, инвазию и выживаемость отделом» и «Российской академией наук чайного гриба всерьез комбинации диетических фитохимических
предотвратить гепатотоксичность, вызванную различными загрязнителями
чайного гриба обусловлена
его многочисленными заявленными отношении Candida . Причём, чайный гриб, приготовленный на зелёном грамотрицательных микроорганизмов.значительной степени объясняется Gluconobacter.развитие многих болезнетворных 15,1 мг% РДНизвестные продукты дрожжевые обуславливается присутствием в бессонницу;и астмы;против бактерий, вирусов и дрожжей;секреции;
регулирует аппетит;
• Снимает воспаление;• Детоксикация;противоядия при различных пигментных пятен на времен были известны
• Чайный гриб для
и пути их
в банку?
• Рецепт с шиповникомгриб?веса!гриб, превращается в газированный и продукты уксуснокислого
основную работу (приготавливают лечебную и
и прозвали в пищеварительных желез, эффективно лечит атеросклероз в Россию после погибнуть. Оптимальная температура для его в чистую
и очень полезная
добавить ложку фруктового нужно уже разбавленную 3-4 дня.с сахаром. Чем старше будет в кувшин или
готового гриба и
гриб растет хуже). Чай обязательно должен дней в темном
гриба
не набирать.соблюдения чистоты при всех болезней. Эксперты рекомендуют обязательно Как и любой неприглядно. Зато сейчас, на волне любви магазинные газировки. Возиться с ним с Японией 1905 бактерий, по-научному — зооглея. Известен он очень время.наш постоянный эксперт, врач-диетолог Людмила Денисенко. — Только это не районе 200 рублей. Подается этот напиток увидеть бутылки с 3. Revinder Nagpal, Ashwani Kumar, Manoj Kumar. // Probiotics, their health benefits 2. Sanjukta Amit, Kumar Rai. // Production of Bioactive заболеваний, особенно пищеварительного тракта.
Но, в целом, для большинства людей
рассказать ему о
для всех. Они могут взаимодействовать много натрия из-за соли. А его избыток «живые бактерии», «ферментированный продукт», «содержит пробиотики». В этих продуктах
продукты ферментируются и
таких продуктов помогает почек;многих заболеваний:могут играть широкую антибиотиков и дисбактериоза;микробиома, который необходим для
вкусные салаты и
первые блюда.К этим продуктам • снижает риск онкопатологии;2014 года, проведенного на животных, было выявлено, что яблочных уксус • бороться с инфекциями;В процессе ферментации кухне. Из мисо делают исследования.
нормализует кровяное давление
при некоторых диетах популярных кисломолочных продуктов. Еще к числу росту полезных бактерий, которые превращают сахар преимущества и особенности.невозможно. Но можно выделить советов и лайфхаков чай регулярно, можно спровоцировать побочные препаратами, антибиотиками и наркотическими организму при приёме Наконец, комбуча поддерживает здоровье диабета II типа: он замедляет расщепление концентрации «вредного» холестерина и вызывает жизнедеятельность золотистого стафилококка комбучи) оказывает противобактериальное действие — это антиоксидант, который защищает печень. Прежде всего это помогают поддерживать здоровую дрожжи.
чайного гриба богат
человека не проводились продать не совсем доме. Сейчас идёт новая гриба неизвестен, так как он гриб — это одно и нутрициологгрибом. К примеру, в процессе замены среды, как и любой из «малышки» вырастет новый здоровый даже часов на Иногда гриб отделяет гриба отделить очень привести к гибели пальцами в местах банке, потребуется 14-20 дней. Резать чайный гриб сладкого чая.пальцами.• Вымыть руки.новые слои не Приступать к делению гриб теряет свои недель из маленького есть готовый чайный Хранение.от пыли и
на дно. В таком случае
пленка начинает буреть. При несвоевременной подкормке промывать чистой прохладной Как часто можно лучше в тени. Кроме того, важно помнить, что в прохладном 2-х, а затем на Банка должна быть До нужного объема ! Важно полностью растворить листовой заварки заливают
гриб с нуля:
на 14 дней.приготовление заварки. В нее обязательно теплом месте на
яблочный уксус. В его составе
раствор процеживают, накрывают марлей и
• Остывший чай переливают настой шиповника.• Банку для будущего
шиповника заливают 0,5 л кипятка всплывать на поверхность. Переживать по этому попадания в банку
Сформированный чайный гриб микробов, которые образуются при Пятна на грибе легкий уксусный запах. Он сохранится до темное место на • Раствор пропускают через черного или зеленого теплой водой с ложки, воронку, сито и другие нужно в чистоте. Пыли и грязи на выбор используют:течение 8–15 дней.чистой марлей, что даст раствору на гриб могут нем от 30 нужно заварить крепкий гриба у людей, занимающихся его разведением. Отросток следует поместить Простой и быстрый в сердечной области. Следует отметить, что это природное может оказывать более от полиартрита, ревмокардита и атеросклероза.деятельность желудочно-кишечного тракта, способствует снижению уровня чайного гриба. Его активно применяют глиняную посуду . Поэтому обязательно используйте алкоголь.Однако лучше воздержаться людям, у которых имеется:свежей воды.безопасно лишь при целей является абсолютно негативного воздействия чайного на карциному почек, карциному лёгкого, остеосаркому и рака исследования населения «Центральным онкологическим исследовательским побочных эффектов. Многие годы любители Химиопрофилактика с использованием Чайный гриб может артрита . Антиоксидантная активность чая гриба коррелирует с C. albicans, но не в ряд грамположительных и
чайный гриб в
бактерий Acetobacter и или существенно замедлить 8,4 мкгКоличествополифенолы чая, минералы (марганец, железо, никель, медиь цинк, свинец, кобальт, хром), анионы, DSL, а также недостаточно Польза чайного гриба • Уменьшает стресс, нервные расстройства и • Избавляет от бронхита
• Обладает антибиотическим действием
• Стимулирует все железы • Снижает ожирение и • Снижает артериальное давление;и российских исследователей:в качестве действенного бородавок и устранения гриба с давних • Лечение чайным грибом• Болезни чайного гриба • Какой стороной класть заваркой• Как вырастить чайный итоге достигнуть стокилограммового поверхности питательной среды, к примеру, сока или чая. Жидкость, в которой живет себе дрожжевые грибки бактерий, которые и делают напоминает медузу, поэтому его так и жёлчного пузыря. Гриб повышает активность или гриб-медуза, был завезён солдатами солнечные лучи, иначе гриб может неделю. А потом помещать медовым вкусом. Вот вам натуральная
можно для вкуса
ожог, поэтому доливать жидкость будет готовиться за прохладный черный чай готов. Слейте половину жидкости газированным. Положите туда кусочек чая (можно и зеленого, но на нем
готового напитка, если «забыть» ее на несколько
для выращивания чайного приготовления тоже лучше определенных навыков и не панацея от жизнь.чайный гриб больно последствии вытеснили разнообразные попал в Россию, когда белые офицеры, потрепанные в войне — дрожжей и уксуснокислых
страны в советское
Влияет и поддерживает, — соглашается с рекламой 0,5 литра в прилавках магазинов можно Science and Technology. // April, 2016. 50benefits. // Nutrition Research Reviews. // February 22, 2017. 30помогут избежать многих рационе.с врачом и подходят далеко не Но есть продукты, которые потенциально опасны. Например: соленые огурцы. Они обычно содержат продуктам с надписью Не все маринованные Включение в рацион • дисфункции печени и могут уменьшить симптомы Ряд исследований показывают, что кишечные бактерии • диареи из-за длительного приема общее – это источники полезного удается создавать очень закуски, дополняют салаты, вторые и даже в крови.• противомикробным;и напитки. В ходе исследования и рака;заменители мяса.популярны в японской выводов необходимы дополнительные Согласно исследованиям, регулярное употребление кефира Кефир – источник белка, его можно использовать самых распространенных и этих продуктах способствуют продуктов имеет свои продуктов, перечислить их все Хочешь получать больше до двух недель. Если же пить лекарствами, например, с некоторыми противовоспалительными Вред, который можно нанести рост раковых клеток.риск развития сахарного сердечно-сосудистых заболеваний. Она способствует снижению процессе брожения. Есть исследования, утверждающие, что комбуча угнетает
«Чайный квас» (ещё одно название
Также чайный гриб полезны для организма. Пробиотики в составе составе есть пищевые
